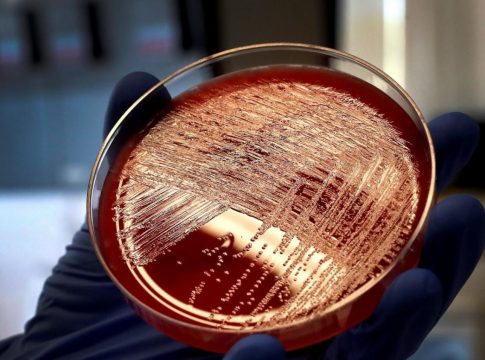

Uno de los problemas que trae el verano son las intoxicaciones alimenticias y, una de las más graves, es la listeria. La última alarma sanitaria ha sido la del grupo catalán Salgot ya que se ha encontrado presencia de esta bacteria en varios lotes de butifarra negra.
Quizás, para entender la gravedad de consumir alimentos contaminados por la listeria, debemos saber de qué se trata. La listeria es una bacteria que está muy presente en la naturaleza. A diferencia de otros gérmenes, ha aprendido a resistir diferentes condiciones ambientales. De hecho, es una de las pocas bacterias patógenas es capaz de multiplicarse activamente en la nevera. Aguanta temperaturas desde los -4 grados a los 37. Para combatirla, se deben cocer los alimentos a más de 70 grados para poder matarla.
Aunque en España los casos de contaminación por listeria son menos de 50 casos, es en verano cuando aumentan. La Listeria monocytogenes provoca una de las infecciones alimentarias más graves, la listerioris, una enfermedad gastrointestinal que presenta una mortalidad de entre el 20 y el 30%. Es especialmente perjudicial en personas mayores, población con un sistema inmune debilitado o embarazadas.
España tiene unos exhaustivos controles sanitarios tanto externos como internos. Estos controles sumados al funcionamiento del Sistema Coordinado de Intercambio Rápido de Información hacen que los productos afectados sean detectados rápidamente y retirados de los establecimientos para el consumo.
La falta de higiene y de desinfección ayuda a que se formen colonias de listeria
La seguridad alimentaria de España es muy buena, es por eso que casi no aparecen brotes de esta bacteria. Sin embargo, la listeria sabe camuflarse muy bien en las máquinas industriales de alimentación, y es por eso que de vez en cuando saltan algunos de estos casos.
MAGRUDIS, EL CASO MÁS GARVE HASTA LA FECHA
El más reciente ha sido en el de la compañía de embutidos Salgot. Tal y como alertaron las autoridades sanitarias de Cataluña a través de la Agencia Española de Seguridad Alimentaria y Nutrición. Al parecer, un cliente realizó un autocontrol en un lote de butifarra negra tradicional.
En el comunicado lanzado por Salgot, la compañía afirma que “con la información disponible no hay constancia en España de ningún caso notificado asociado a esta alerta”. En concreto, los lotes contaminados han sido Botifarra negra: 211804 y 212019, Botifarra negra Tradicional: 211804 y Bull de llengua: 212017.
Sin embargo, el brote de listeria más grande producido en nuestro país fue el de la carne mechada producida por Magrudis en 2019. La provincia más afectada fue Andalucía, donde dejó más de 200 personas afectadas y provocó cuatro muertes y seis abortos.
Los productos contaminados presentaban una concentración de listeria monocytogenes que excedía entre 3.700 y 149.900 veces el límite de contaminación máxima tolerable. El gerente de Magrudis y su hijo, que era el testaferro, se encuentran en prisión.
La falta de higiene o no desinfectar correctamente las máquinas, las herramientas y las superficies ayuda a que se creen colonias de estas bacterias. Es por eso que una exhaustiva higiene ayuda a que los productos alimentarios no se contaminen, especialmente en verano.